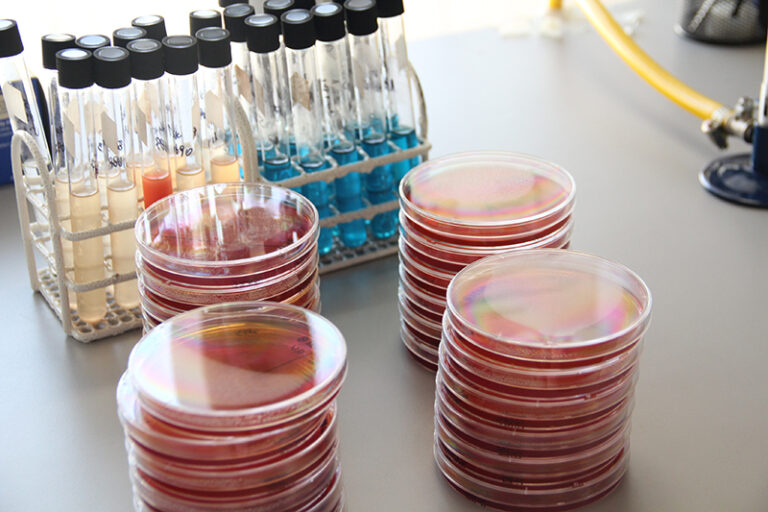

Karla Grunewaldt lanza su primer álbum en público y agota las entradas en 15 minutos

[vc_column][vc_single_image image=”17607″ img_size=”full” alignment=”center”][/vc_column][/vc_row][vc_column][vc_column_text]Apenas se pusieron a la venta las entradas del concierto, se supo que sería todo un éxito….